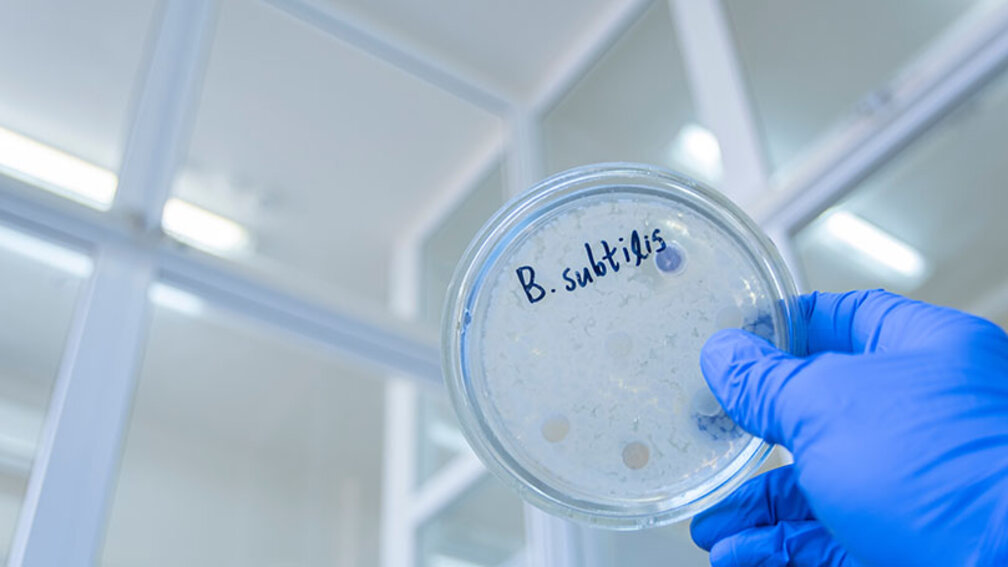
Mikrobe des Jahres Unangenehme Gespräche im Apothekenteam Neue
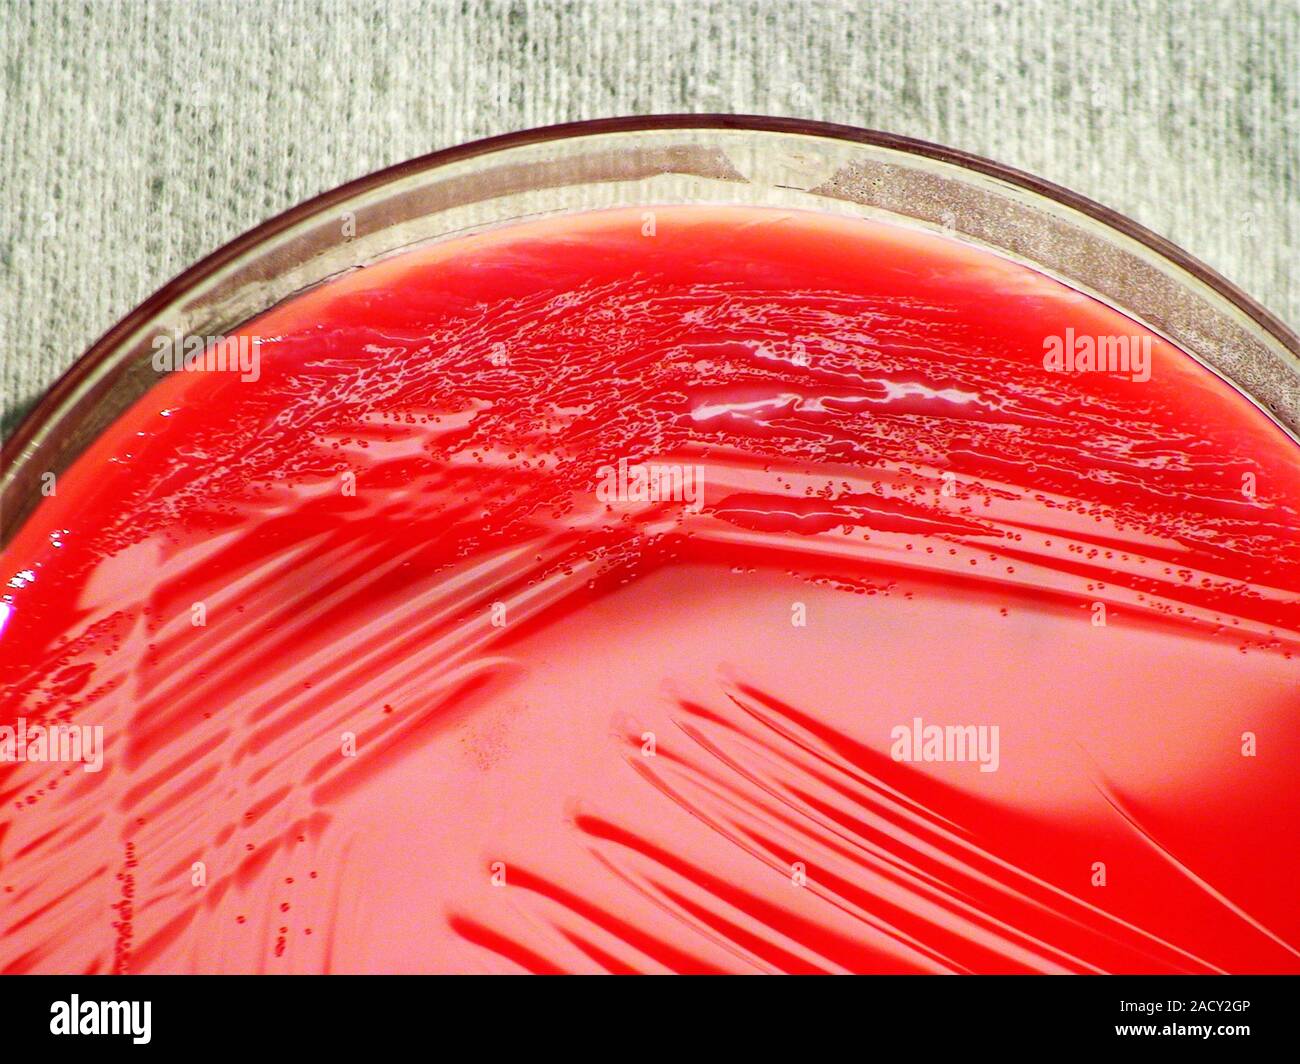
Pseudomonas fluorescens Bakterien Kultur. Petrischale mit Blut der

Pseudobaccharis es un género de plantas de la familia de las asteráceas. Comprende 10 especies descritas.[2]
Taxonomía
El género fue descrito por Ángel Lulio Cabrera y publicado en Notas del Museo de la Plata, Botánica 9(46): 246–247, en 1944.[3]
Especies aceptadas
A continuación se brinda un listado de las especies del género Pseudobaccharis aceptadas actualmente, ordenadas alfabéticamente. Para cada una se indica el nombre binomial seguido del autor, abreviado según las convenciones y usos.[1]
- Pseudobaccharis acaulis (Wedd. ex R.E.Fr.) Cabrera, 1944
- Pseudobaccharis densa (N.E.Br.) V.M.Badillo, 1946
- Pseudobaccharis macrophylla (Dusén) Malag., 1952
- Pseudobaccharis retamoides (Phil.) Cabrera, 1944
- Pseudobaccharis spartioides (Hook. y Arn. ex DC.) Cabrera, 1944
- Pseudobaccharis tenella (Hook. y Arn.) Cabrera, 1944
Referencias